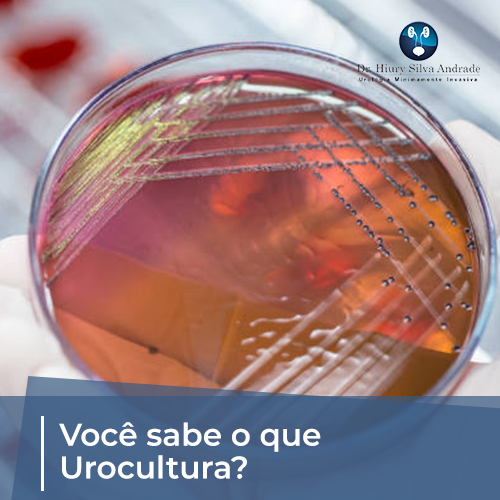
urocultura com antibiograma

Você já fez um exame de urina comum e o médico pediu uma urocultura? Muita gente confunde os dois, mas a diferença é crucial. Enquanto o exame de urina tipo 1 só dá um alerta, a urocultura é a prova definitiva que identifica o invasor.
Se você já teve infecção urinária e o tratamento não funcionou, a urocultura com antibiograma é a chave para descobrir por quê. Esse exame mostra exatamente qual bactéria está causando o problema e, de quebra, quais antibióticos vão matá-la de verdade.
Urocultura: o padrão ouro para diagnosticar infecção urinária
A urocultura, ou cultura de urina, é o exame laboratorial mais confiável para confirmar uma infecção do trato urinário (ITU). Diferente do exame de urina simples, ela não apenas detecta sinais de inflamação, mas isola e identifica o microrganismo causador — na maioria das vezes a famosa Escherichia coli.
O grande diferencial está no antibiograma, que testa a sensibilidade da bactéria a vários antibióticos. Isso é essencial para evitar tratamentos ineficazes, principalmente em casos de cistite de repetição ou pielonefrite, onde a escolha errada pode levar a complicações sérias.
Para garantir um resultado preciso, a coleta segue regras rígidas: higiene íntima com água e sabão, desprezar o primeiro jato de urina e colher o jato médio em um frasco estéril. O ideal é usar a primeira urina da manhã, mas qualquer amostra com pelo menos 4 horas de retenção na bexiga serve.
Urocultura: O Detetive Invisível das Infecções Urinárias em 2026
Vamos combinar, ninguém gosta de sentir dor ou desconforto, especialmente quando se trata de algo tão íntimo quanto o sistema urinário. Mas a verdade é que as infecções do trato urinário (ITU) são mais comuns do que a gente imagina. E para desvendar quem é o culpado por trás desses incômodos, a urocultura se consolida em 2026 como o exame mais confiável. Ele é o verdadeiro ‘padrão ouro’ para identificar o que está acontecendo ali dentro.
Diferente de um simples exame de urina tipo 1, a urocultura é um exame laboratorial que vai fundo. Ela não só confirma se há uma infecção, mas também mostra qual microrganismo, geralmente uma bactéria como a temida _Escherichia coli_, está causando o problema. É como ter um detetive particular para a sua saúde urinária, garantindo que o tratamento seja certeiro.
| Exame | Finalidade Principal | Agente Comum | Teste Associado | Preparo Essencial | Tempo de Resultado | Indicativo de Infecção |
| Urocultura | Identificar microrganismos em infecções urinárias | _Escherichia coli_ | Antibiograma | Higiene e jato médio de urina | 3-5 dias úteis | > 100.000 UFC/mL |
O que é urocultura
A urocultura, também conhecida como cultura de urina, é o exame de laboratório que permite identificar com precisão a presença de bactérias ou fungos no sistema urinário. Ele é fundamental quando há suspeita de infecção, pois vai além da simples detecção de células ou substâncias na urina. O objetivo é isolar o agente causador para um diagnóstico assertivo.
Pode confessar, muitas vezes um exame de urina comum pode dar um resultado inconclusivo. É aí que a urocultura entra em cena, oferecendo uma análise detalhada que vai direto à raiz do problema. Ela é a ferramenta que guia o médico para o tratamento correto.
Urocultura com antibiograma

Olha só, a urocultura raramente vem sozinha. Ela é quase sempre acompanhada do antibiograma. Esse teste é o braço direito da urocultura, pois ele avalia quais antibióticos são realmente eficazes contra a bactéria encontrada. Sem ele, o médico estaria escolhendo um remédio no escuro.
O antibiograma é crucial para evitar a resistência bacteriana e garantir que o tratamento seja rápido e eficaz. É a garantia de que você vai tomar o remédio certo.
A combinação de urocultura e antibiograma é o que chamamos de ‘padrão ouro’ para o diagnóstico e tratamento de infecções urinárias. Ela nos dá a certeza do que estamos combatendo e como combatê-lo da melhor forma possível.
Como fazer a coleta de urina
O preparo para a coleta de urina para urocultura é um dos pontos mais críticos para um resultado confiável. Qualquer contaminação externa pode levar a um diagnóstico errado, e ninguém quer isso, certo? A higienização correta da região genital é o primeiro passo, usando água e sabão neutro.
O ideal é coletar o jato médio da urina. Isso significa desprezar o primeiro fluxo e coletar a urina que vem depois, diretamente no frasco estéril fornecido pelo laboratório. Se possível, a primeira urina da manhã é a mais indicada por ser mais concentrada, mas se não der, um período de 4 horas sem urinar já ajuda.
- Lave bem as mãos.
- Higienize a região íntima com água e sabão neutro.
- Despreze o primeiro jato de urina.
- Colete o jato médio em frasco estéril.
- Feche bem o frasco e entregue ao laboratório.
Interpretação do resultado positivo

Um resultado de urocultura positivo significa que foram encontradas bactérias em quantidade significativa na sua urina. Geralmente, considera-se um crescimento acima de 100.000 Unidades Formadoras de Colônias por mililitro (UFC/mL) como indicativo de infecção ativa. Esse número é o que o laboratório usa como parâmetro.
Mas preste atenção: um resultado positivo não é motivo para pânico, e sim para ação. Ele é a informação que o médico precisa para iniciar o tratamento correto. O laudo virá detalhando a bactéria e, se o antibiograma foi feito, quais antibióticos funcionam.
Bactérias na urina: causas comuns
A causa mais comum de bactérias na urina, especialmente em mulheres, é a _Escherichia coli_ (E. coli). Essa bactéria, que vive normalmente no nosso intestino, pode acabar migrando para a uretra e, consequentemente, para a bexiga, causando a temida cistite. A anatomia feminina facilita essa aproximação.
Outros fatores podem contribuir, como o uso de cateteres, certas condições médicas (diabetes, por exemplo) e até mesmo a atividade sexual. O importante é entender que a presença de bactérias não é normal e precisa ser investigada.
Tempo para resultado da urocultura
A urocultura exige um tempo para que os microrganismos cresçam em laboratório. Por isso, o resultado não sai na hora. Geralmente, o laudo fica pronto em cerca de 3 a 5 dias úteis após a coleta. Esse prazo é necessário para garantir que qualquer crescimento bacteriano seja detectado.
É fundamental ter paciência nesse período. O médico pode, em alguns casos, iniciar um tratamento empírico (com base nos sintomas e na probabilidade) antes mesmo do resultado sair, mas a urocultura é que vai confirmar e direcionar o tratamento definitivo. Acompanhe o resultado no laboratório.
Urocultura para cistite e pielonefrite
Quando falamos de cistite (infecção na bexiga) ou pielonefrite (infecção nos rins), a urocultura é o exame de escolha para o diagnóstico. Ela confirma a presença da infecção e identifica o agente causador, o que é vital para o sucesso do tratamento. Uma infecção renal, por exemplo, é mais séria e exige uma abordagem rápida e precisa.
O diagnóstico preciso, guiado pela urocultura, evita que infecções urinárias se tornem crônicas ou causem complicações mais graves, como danos aos rins. É o exame que garante que o tratamento para cistite ou pielonefrite seja realmente eficaz.
Urocultura padrão ouro no diagnóstico
A urocultura é considerada o ‘padrão ouro’ porque é o método mais confiável para diagnosticar infecções do trato urinário. Ela oferece uma identificação específica do microrganismo e sua sensibilidade a antibióticos, algo que outros exames de urina não conseguem fazer com a mesma precisão.
Entender a urocultura como o exame definitivo para ITU nos ajuda a valorizar a importância de um preparo correto na coleta e de seguir as orientações médicas. É a base para um tratamento eficaz e para a recuperação da saúde.
O Veredito de 2026: Urocultura, a Guardiã da Saúde Urinária
Em 2026, a urocultura não é apenas um exame, é um aliado indispensável na manutenção da saúde. Sua capacidade de identificar com precisão o inimigo e guiar o tratamento mais eficaz a consolida como um pilar no combate às infecções urinárias. A tecnologia avança, mas a confiabilidade deste exame permanece inabalável.
Podemos esperar que a urocultura continue evoluindo, talvez com resultados ainda mais rápidos ou com a detecção de microrganismos mais raros. Mas sua essência como ‘padrão ouro’ para infecções urinárias está garantida. É a ferramenta que nos dá segurança e direcionamento para uma vida mais saudável e livre de desconfortos.
O que ninguém conta sobre a coleta ideal
O horário faz diferença. A primeira urina da manhã é a mais concentrada e aumenta a chance de detectar bactérias mesmo em infecções com baixa carga microbiana.
Não interrompa o jato. Colete o jato médio após desprezar o primeiro jato – isso reduz a contaminação por células da uretra e da pele.
Higienize sem exageros. Use água e sabão neutro; não use antissépticos ou lenços umedecidos, pois podem inibir o crescimento bacteriano na cultura.
Leve ao laboratório em até 2 horas. A urina é um excelente meio de cultura. Se não for processada rapidamente, as bactérias se multiplicam e o resultado fica falso-positivo.
Evite antibióticos antes do exame. Se já iniciou o tratamento, a urocultura pode vir negativa mesmo com infecção ativa – o ideal é colher antes da primeira dose.
Perguntas frequentes sobre urocultura
Precisa estar em jejum para fazer urocultura?
Não, o jejum não é necessário. Apenas evite urinar por pelo menos 4 horas antes da coleta para garantir volume e concentração adequados.
Urocultura e sumário de urina são a mesma coisa?
Não. O sumário (tipo 1) é um exame de triagem que avalia leucócitos, nitrito e outros parâmetros. Já a urocultura identifica o microrganismo específico e sua sensibilidade a antibióticos.
Quanto tempo leva para sair o resultado da urocultura?
O laudo costuma ficar pronto entre 3 e 5 dias úteis. Esse prazo é necessário para que as bactérias cresçam em meio de cultura e sejam identificadas.
A urocultura continua sendo o padrão ouro para o diagnóstico de infecções urinárias, superando qualquer exame de triagem. Quando bem indicada e corretamente coletada, ela elimina dúvidas e direciona o tratamento com precisão.
Se você apresenta sintomas como ardência, urgência urinária ou dor lombar, não hesite em solicitar esse exame ao seu médico. Um diagnóstico assertivo evita o uso inadequado de antibióticos e complicações renais.
A medicina laboratorial avança, mas a urocultura mantém sua relevância pela capacidade de individualizar a terapia. Em 2026, com a crescente resistência bacteriana, esse exame se torna ainda mais indispensável para a saúde do trato urinário.

